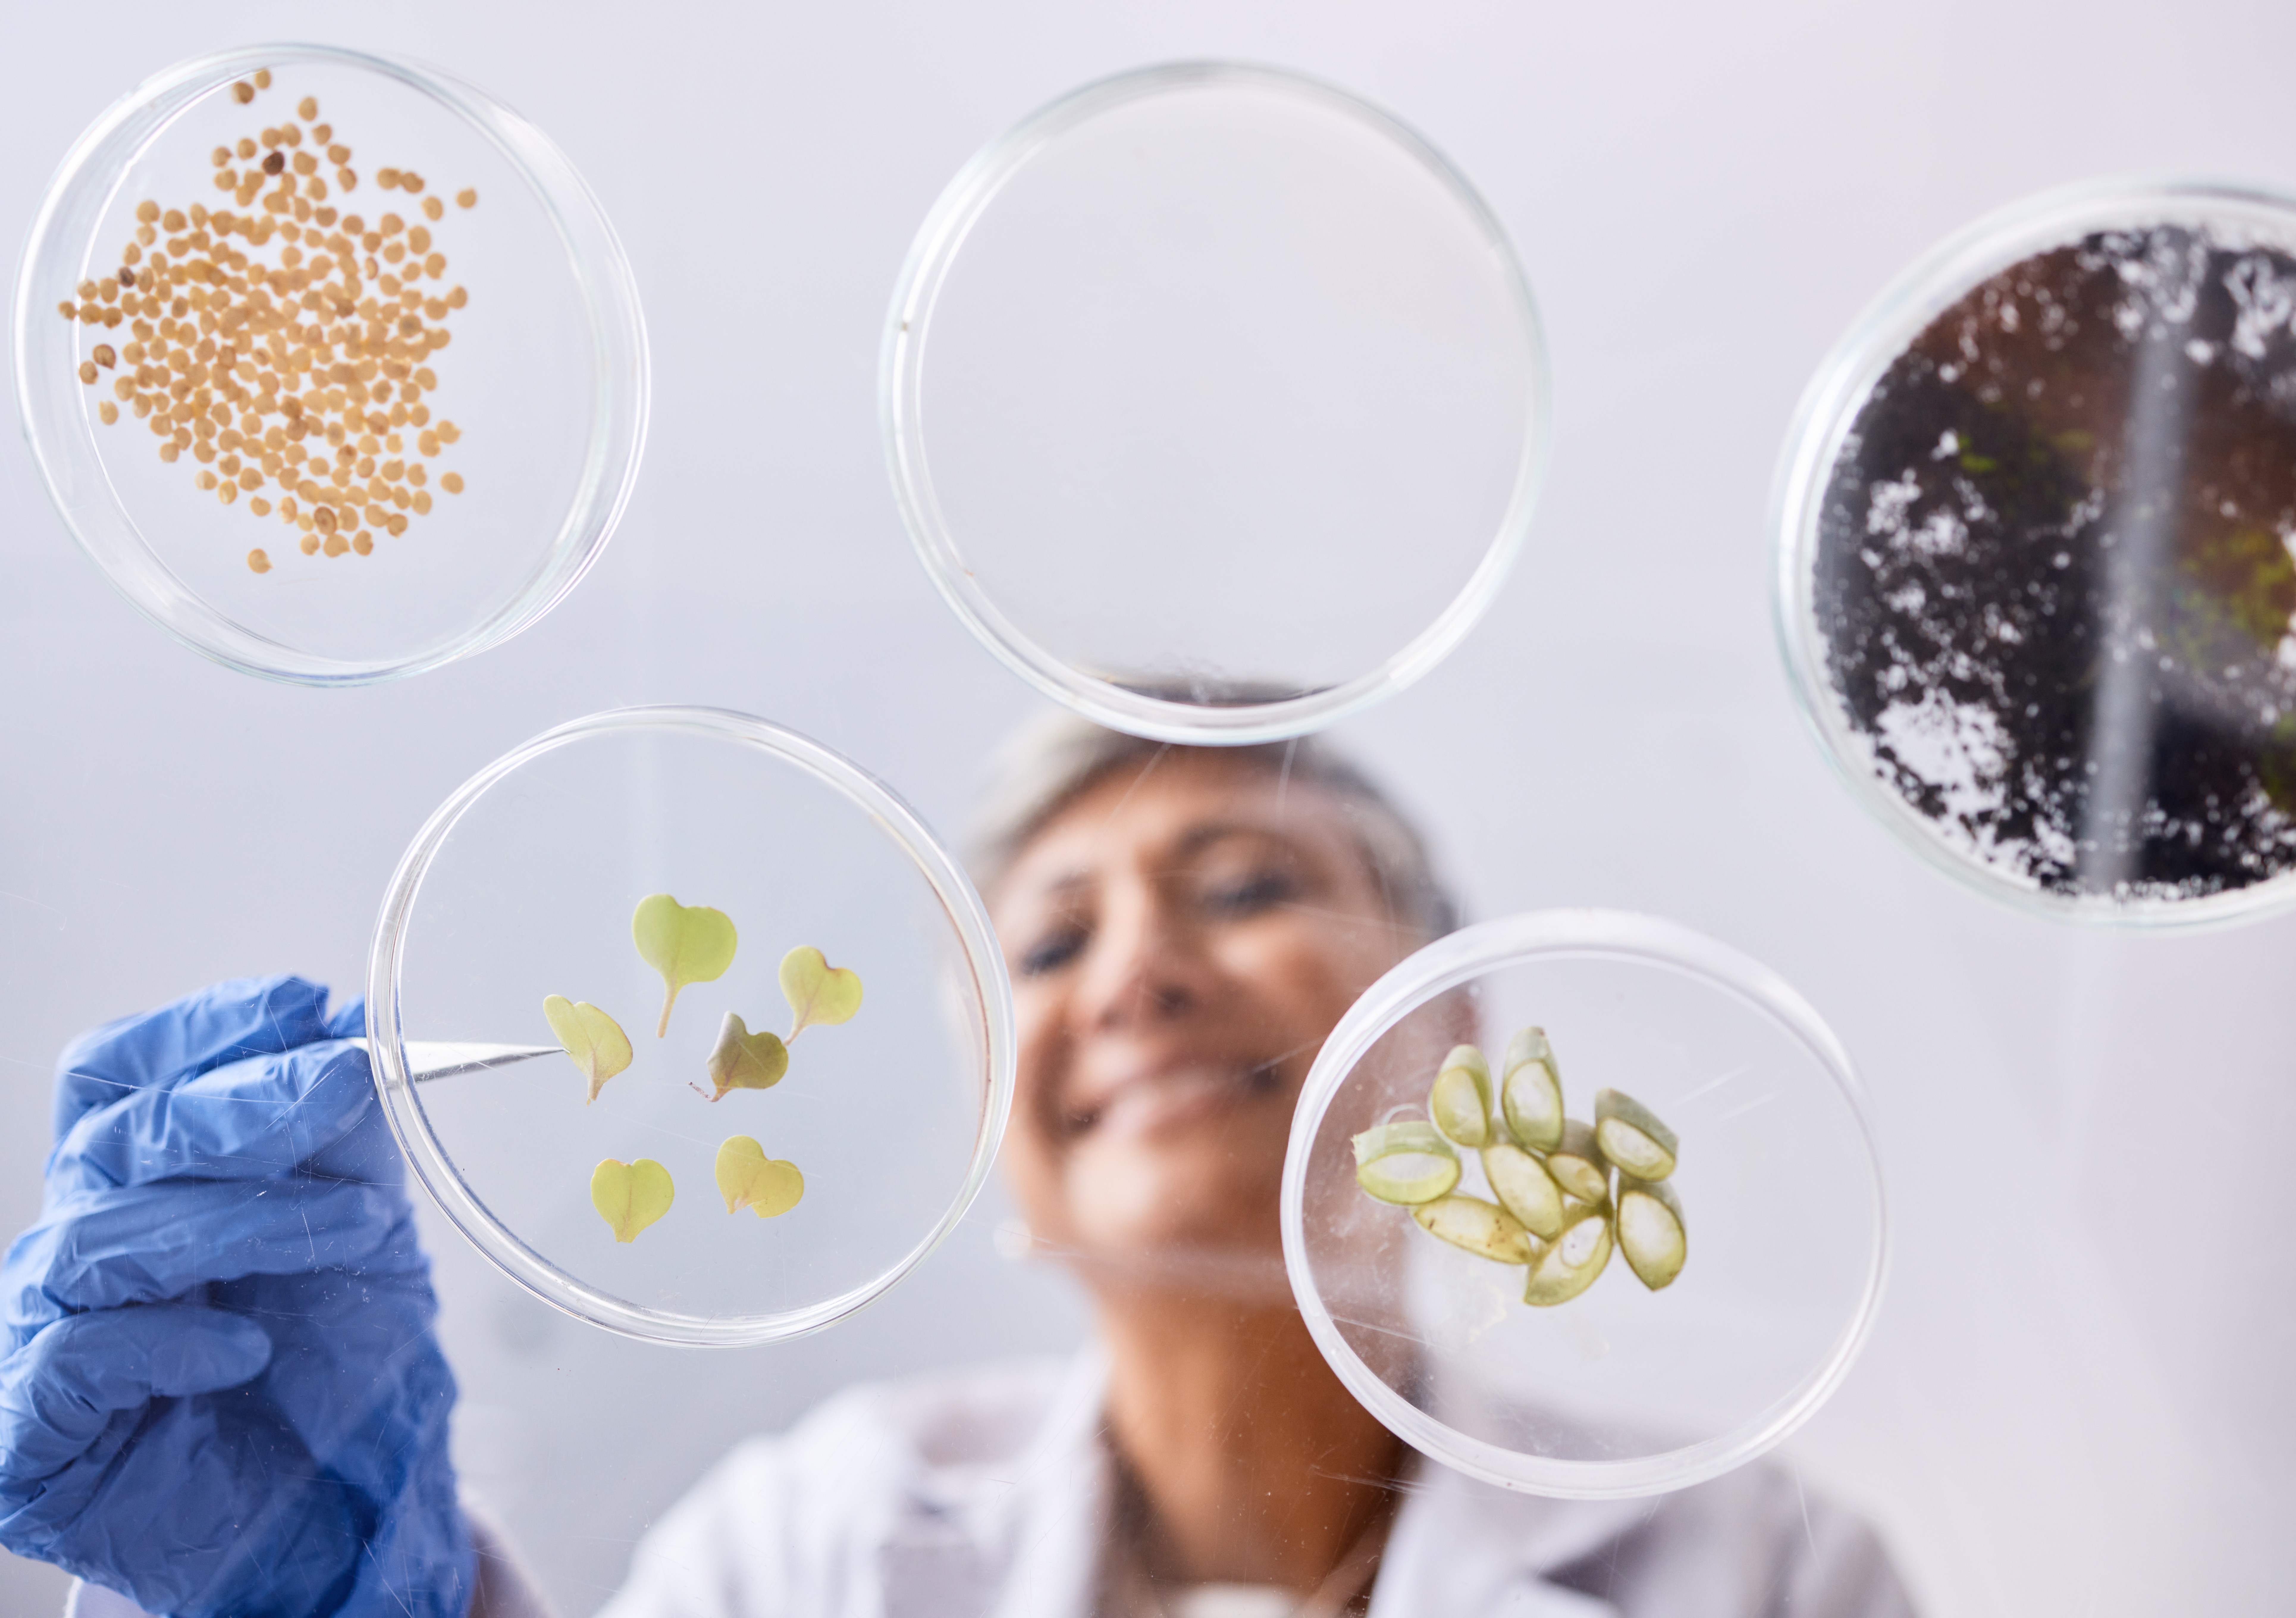
The image featured at the top of the about us page #1
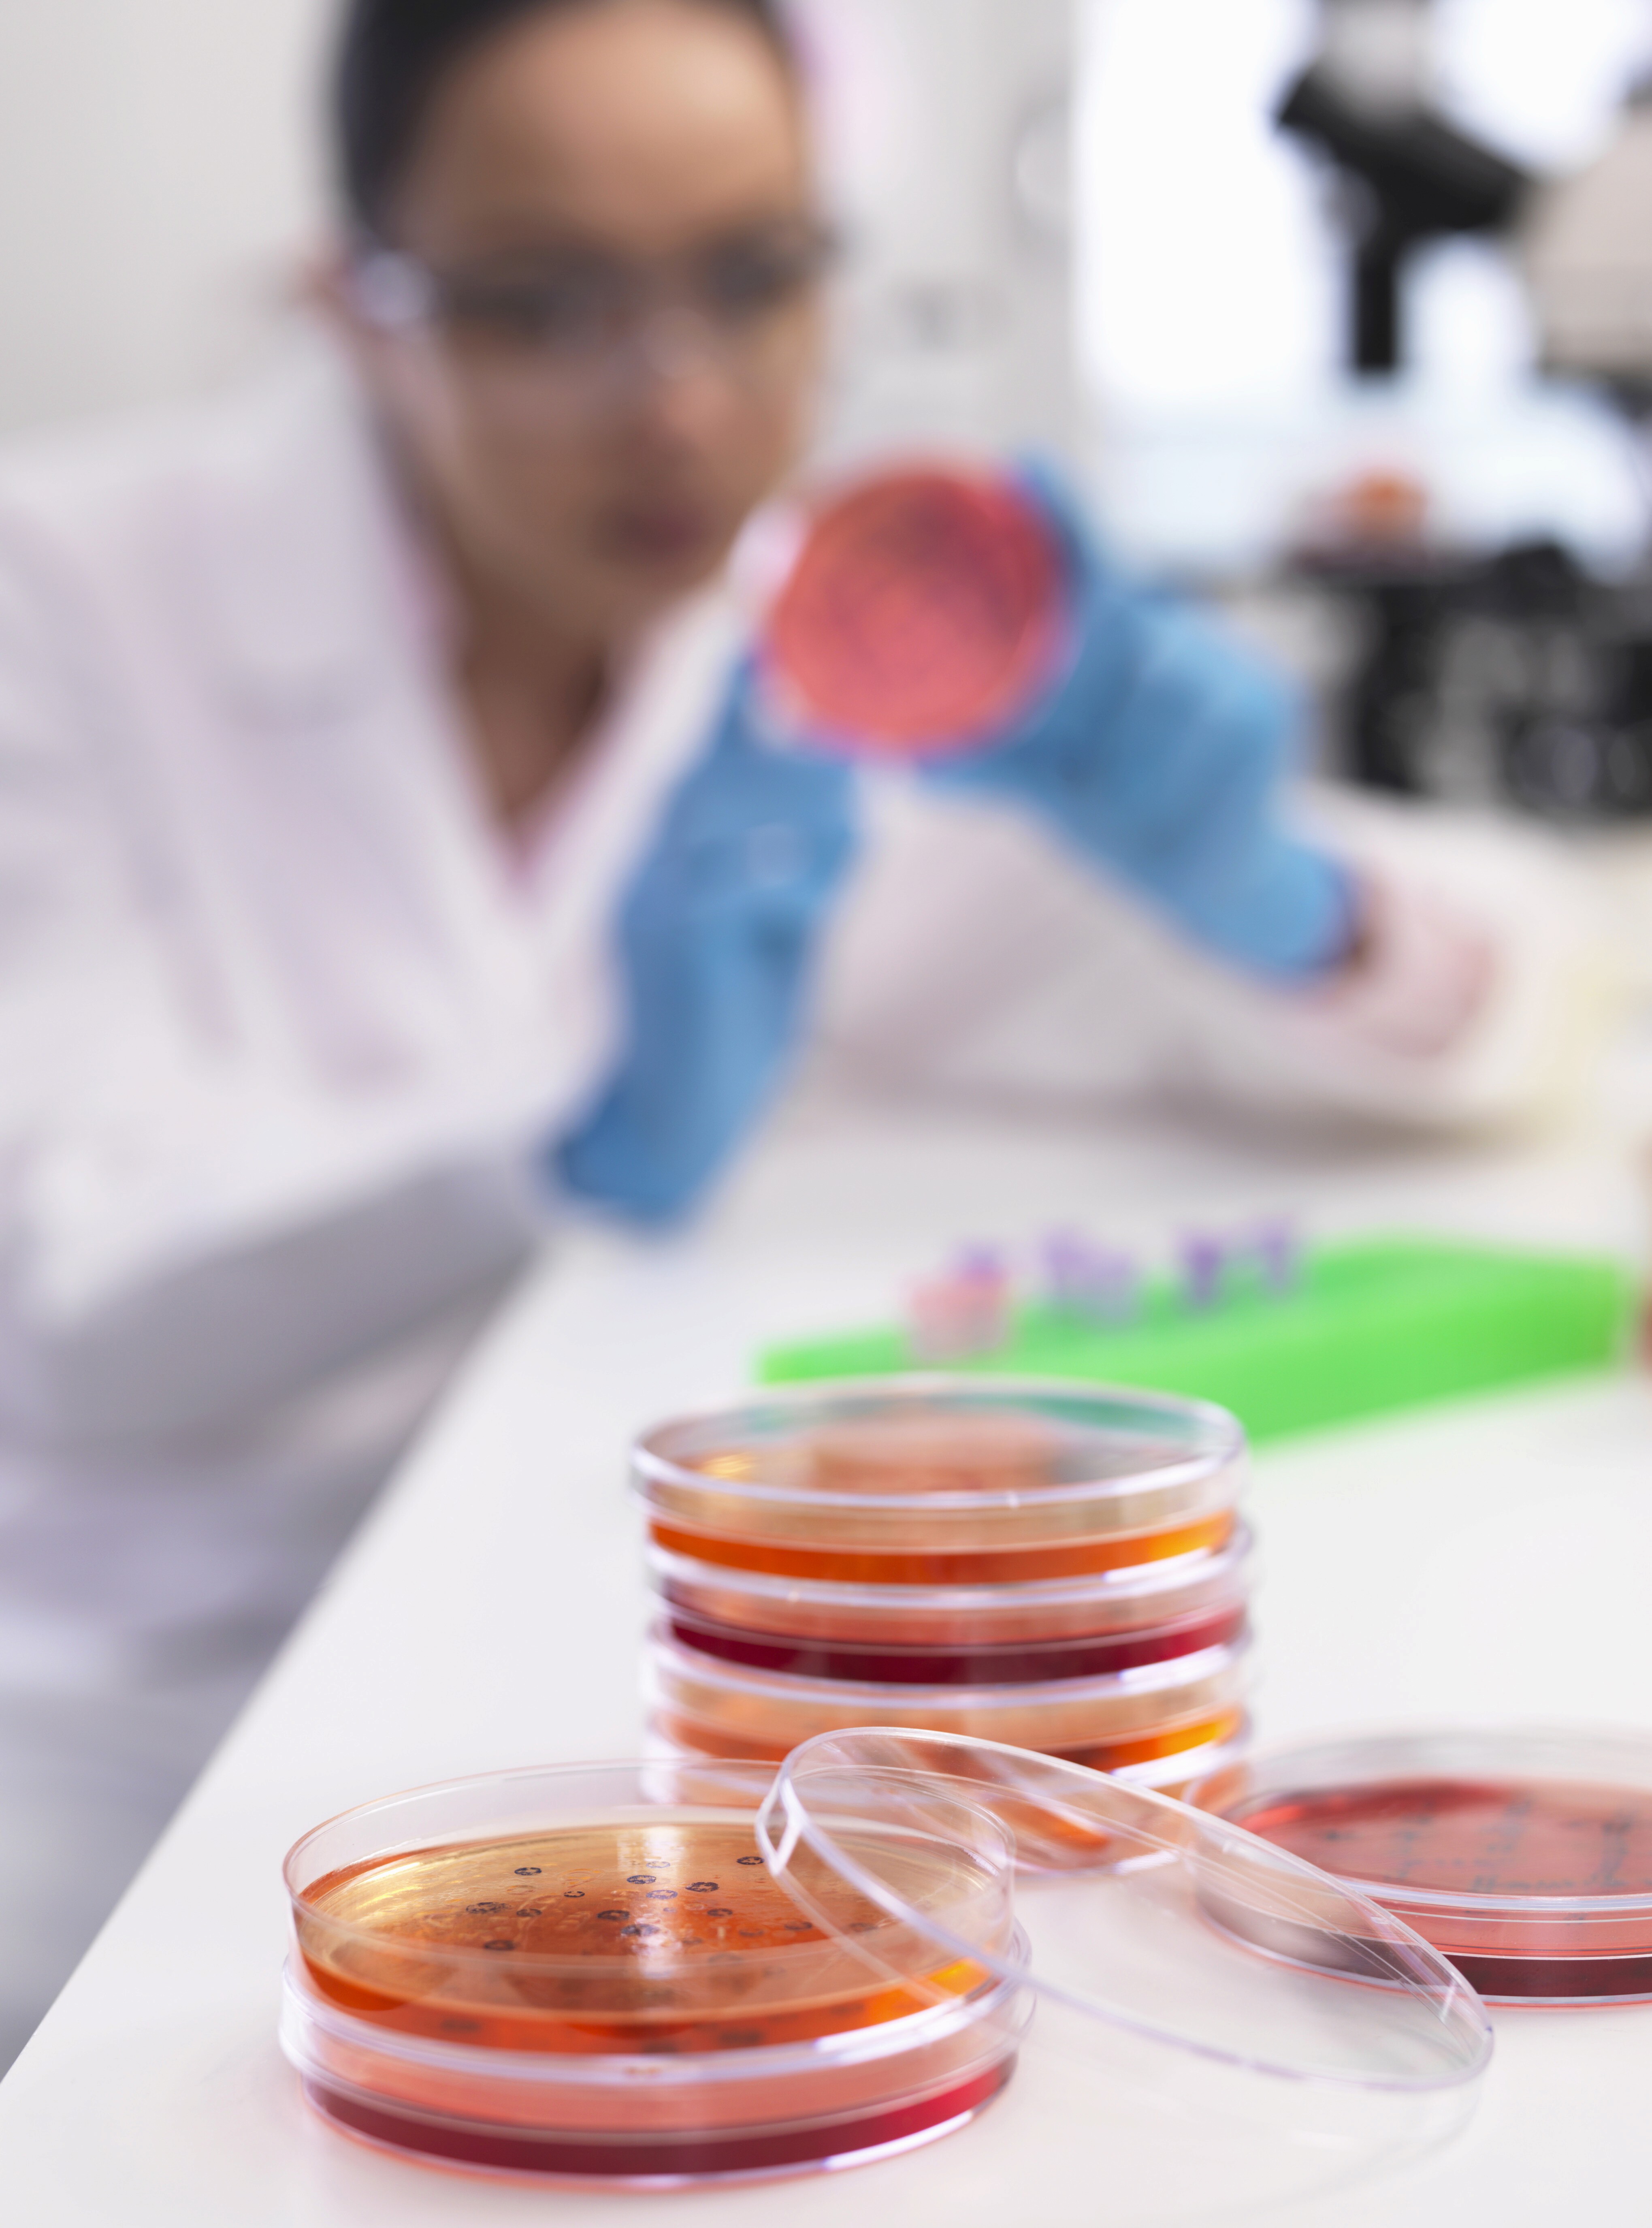
The image featured at the top of the about us page #2

Food and Drinks
Food and Drinks
lab
lab
Pharmilabprovidestechnicalandregulatoryservicestosupportthedevelopment,labelling,andcommercializationoffoodandbeverageproducts.
Pharmilabprovidestechnicalandregulatoryservicestosupportthedevelopment,labelling,andcommercializationoffoodandbeverageproducts.
Pharmilabisahighlyexperiencedproviderofcompletesolutionsforthedevelopment,regulation,andmarketplacementofcosmeticproducts,guaranteeinglegalcomplianceandqualityateverystep.
Within-depthknowledgeofbothEuropeanandnationalfoodlegislation,weensurethatyourproductsmeetalllegalrequirements—fromcompositiontonutritionalclaims—guaranteeingquality,safety,andconsumertrustinthemarket.
Within-depthknowledgeofbothEuropeanandnationalfoodlegislation,weensurethatyourproductsmeetalllegalrequirements—fromcompositiontonutritionalclaims—guaranteeingquality,safety,andconsumertrustinthemarket.
Fromformulationtolabelling,includingsafetyassessmentandregulatorysubmissions,weoverseeeverystepwithscientificrigorandup-to-dateindustryknowledge.

Microbiology and Physicochemicals
Microbiology and Physicochemicals
Allow the detection and quantification of pathogenic micro-organisms and indicator micro-organisms, complying with Regulation (EC) No 852/2004 of the European Parliament and of the Council of 29 April 2004 on, among others, microbiological criteria for food;
Allow the detection and quantification of pathogenic micro-organisms and indicator micro-organisms, complying with Regulation (EC) No 852/2004 of the European Parliament and of the Council of 29 April 2004 on, among others, microbiological criteria for food;
Allow the detection and quantification of pathogenic micro-organisms and indicator micro-organisms, complying with Regulation (EC) No 852/2004 of the European Parliament and of the Council of 29 April 2004 on, among others, microbiological criteria for food;

Physical and Chemical
Analyses
Physical and Chemical Analyses
They allow the characterisation of a food through the analysis of its chemical composition, physical and sensory properties, including the identification and quantification of additives, determination of contaminants content, control of the risk of allergens, and nutritional analysis within the meaning of Regulation (EU) No 1169/2011 of 25 October.
They allow the characterisation of a food through the analysis of its chemical composition, physical and sensory properties, including the identification and quantification of additives, determination of contaminants content, control of the risk of allergens, and nutritional analysis within the meaning of Regulation (EU) No 1169/2011 of 25 October.
They allow the characterisation of a food through the analysis of its chemical composition, physical and sensory properties, including the identification and quantification of additives, determination of contaminants content, control of the risk of allergens, and nutritional analysis within the meaning of Regulation (EU) No 1169/2011 of 25 October.
Conquer the world
with your brand
Fill out the form today and experience expert services

Conquer the world
with your brand
Fill out the form today and experience expert services

Conquer the world
with your brand
Fill out the form today and experience expert services
